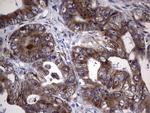
MTDH Antibody in Immunohistochemistry (Paraffin) (IHC (P))

Search
OriGene
MTDH Monoclonal Antibody (OTI1B6), TrueMAB™
{{$productOrderCtrl.translations['antibody.pdp.commerceCard.promotion.promotions']}}
{{$productOrderCtrl.translations['antibody.pdp.commerceCard.promotion.viewpromo']}}
{{$productOrderCtrl.translations['antibody.pdp.commerceCard.promotion.promocode']}}: {{promo.promoCode}} {{promo.promoTitle}} {{promo.promoDescription}}. {{$productOrderCtrl.translations['antibody.pdp.commerceCard.promotion.learnmore']}}
产品信息
TA804490
种属反应
宿主/亚型
分类
类型
克隆号
抗原
偶联物
形式
浓度
纯化类型
保存液
内含物
保存条件
运输条件
靶标信息
Metadherin (Metastasis adhesion protein), also known as MTDH, LYsine-RIch CEACAM1 co-isolated (LYRIC), is a novel protein that localizes with the tight junction proteins ZO-1 and occludin in polarized epithelial cells. At the tight junction, it acts not as a structural component, but is rather recruited during the maturation of the tight junction complex. Metadherin is overexpressed in breast cancer tissue and breast tumor xenografts, while much lower levels are expressed in normal breast tissue. Metadherin binds to lung vasculature, one of the four common sites of breast cancer metastasis, through a C-terminal segment in the extracellular domain; blocking this lung-homing domain with antibodies or inhibiting metadherin with siRNA has been reported to inhibit breast cancer metastasis.
仅用于科研。不用于诊断过程。未经明确授权不得转售。
篇参考文献 (0)
生物信息学
蛋白别名: 3D3/LYRIC; AEG-1; astrocyte elevated gene 1; Astrocyte elevated gene-1 protein; LYRIC/ MTDH; Lysine-rich CEACAM1 co-isolated protein; Metadherin; Metastasis adhesion protein; Protein LYRIC
基因别名: 3D3; AEG-1; AEG1; LYRIC; LYRIC/3D3; MTDH
UniProt ID: (Human) Q86UE4
Entrez Gene ID: (Human) 92140